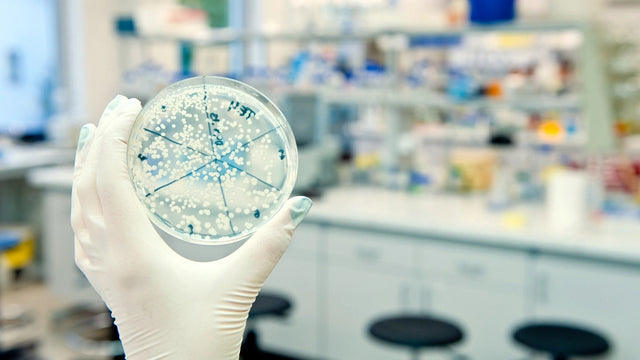

Specialisatie in bioconstructie

Informatie aanvragen


Temario
Descargar temario en PDFPlan de estudios
Samenvatting
Deze specialisatie in bioconstructie combineert de disciplines van het ontwerp en het beheer van architecturale projecten volledig met een duurzame aanpak. Studenten verwerven kennis over duurzame materialen, natuurlijke constructietechnieken en hulpmiddelen die hen voorbereiden op een carrière in de voorhoede van ecologische architectuur. Als gevolg hiervan zullen studenten bereid zijn om duurzame bouwprojecten te leiden, zowel in architectuur- als engineeringstudies, als in interieurontwerpstudies, waardoor de huidige uitdagingen in de industrie effectief worden aangepakt, wat bijdraagt aan de ontwikkeling van meer milieuvriendelijke gebouwen.
Doelen
Professionele mogelijkheden
Om je voor te bereiden
Deze specialisatie in bioconstructie bereidt u voor op het leiden van duurzame bouwprojecten, de beste ecologische ontwerppraktijken toepassen en ecoamigeerbare processen gebruiken die integreren in de bouw. Bij het voltooien van deze formatie bent u klaar om de huidige uitdagingen van de bio -architectuurindustrie aan te gaan en bij te dragen aan het creëren van meer milieuvriendelijke respectvolle gebouwen.
Aan wie is het gericht?
Deze specialisatie in bioconstructie is ontworpen voor architecten, ingenieurs, interieurontwerpers en professionals op het gebied van bouw die zich willen specialiseren in duurzame architectuur en bioconstructie. Het is ook geschikt voor studenten in een loopbaan met betrekking tot projectontwerp en -beheer.

Onze methodologie combineert technologie, pedagogiek en empathie voor leren op maat.
Jij bepaalt het tempo, bepaalt het pad en kunstmatige intelligentie begeleidt je zodat je beter leert, met betekenis en doel.

Echt gepersonaliseerd leren
Jouw stijl, interesses en niveau bepalen de route. Jij bent het startpunt.

Constructivisme in actie
Ontdek, experimenteer en pas toe. Leren betekent begrijpen, niet onthouden.

AI die u vergezelt en niet stuurt
PHIA, onze kunstmatige intelligentie-assistent begeleidt u zonder uw autonomie te beperken.

Evaluatie zonder druk
Continue en adaptieve feedback. Omdat leren een proces is en geen getal.
Certificación

Diploma van accreditatie van de cursus Bioconstruction Specialisatie met curriculaire waarde uitgegeven door Universidad Da Vinci European Business School

EducaHub-beurzen
Maak uw opleiding toegankelijker: financier tegen 0% rente en ontvang gepersonaliseerde beurzen.
Bij EducaHub vinden we dat onderwijs voor iedereen beschikbaar moet zijn. Om deze reden bieden wij een Scholarship Plan aan dat uw toegang tot praktische, actuele en kwaliteitsvolle trainingen vergemakkelijkt, waardoor economische barrières worden weggenomen.
-25%
Alumni Scholarship: voor voormalige EducaHub-studenten.
-20%
Werkloosheidsbeurs: als u bewijst dat u werkloos bent.
-20%
Large Family Scholarship: voor gezinnen met 3 of meer kinderen.
-20%
Beurzen voor gehandicapten: voor mensen met een handicap ≥33%.
-15%
Emprende Scholarship: voor zelfstandigen die hun activiteit kunnen bewijzen.
-15%
Aanbevolen studiebeurs: als je wordt aanbevolen door een oud-student.
-15%
Groepsbeurs: voor gezamenlijke inschrijvingen van 3 of meer personen.

Een compleet educatief universum, op één enkel platform.
Een intuïtieve omgeving met AI die je begeleidt om autonoom en doelgericht te trainen.

Leer in jouw tempo
Cursussen, masterdiploma's en officiële kwalificaties. 100% online, flexibel en in jouw tempo.

Toegang vanaf elke locatie
24/7 bereikbaar op mobiel, tablet of pc. Jij bepaalt wanneer en hoe je traint.

Phia, je AI-mentor
Het daagt je uit, motiveert je en personaliseert je pad. Leer met een gids die met u mee evolueert.

LX One Plus: Trainen zonder grenzen
Ontgrendel zachte vaardigheden, talen en meer. Ga over op uitgebreide en voortdurende training.